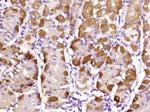
MDFI Antibody in Immunohistochemistry (Paraffin) (IHC (P))

Search
Bioss
MDFI Polyclonal Antibody
{{$productOrderCtrl.translations['antibody.pdp.commerceCard.promotion.promotions']}}
{{$productOrderCtrl.translations['antibody.pdp.commerceCard.promotion.viewpromo']}}
{{$productOrderCtrl.translations['antibody.pdp.commerceCard.promotion.promocode']}}: {{promo.promoCode}} {{promo.promoTitle}} {{promo.promoDescription}}. {{$productOrderCtrl.translations['antibody.pdp.commerceCard.promotion.learnmore']}}
图: 1 / 2
MDFI Antibody (BS-18743R) in IHC (P)

产品信息
BS-18743R
种属反应
宿主/亚型
分类
类型
抗原
偶联物
形式
浓度
规格
纯化类型
保存液
内含物
保存条件
运输条件
靶标信息
MDFI is a transcription factor that negatively regulates other myogenic family proteins. Studies of the mouse homolog, I-mf, show that it interferes with myogenic factor function by masking nuclear localization signals and preventing DNA binding. Knockout mouse studies show defects in the formation of vertebrae and ribs that also involve cartilage formation in these structures. MDFI an also interfere with the DNA-binding activity of Myod family members and plays an important role in trophoblast and chondrogenic differentiation.
仅用于科研。不用于诊断过程。未经明确授权不得转售。
篇参考文献 (0)
生物信息学
蛋白别名: inhibitor of MyoD family a; MyoD family inhibitor; Myogenic repressor I-mf; unnamed protein product
基因别名: I-MF; I-mfa; MDFI
UniProt ID: (Human) Q99750
Entrez Gene ID: (Human) 4188




